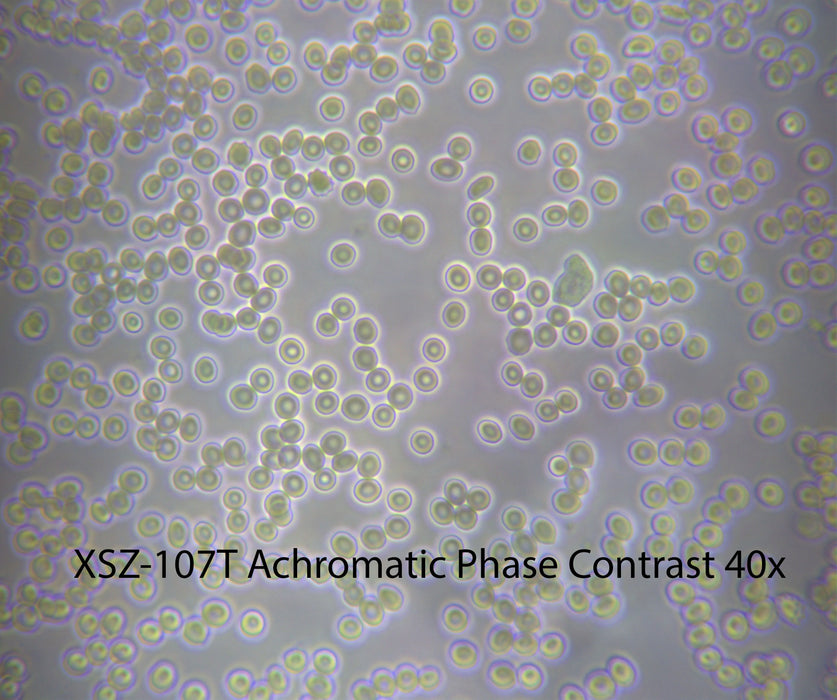

Optico Phase Contrast Kit
by Optico
Original price
$795.00
-
Original price
$795.00
Original price
$795.00
$795.00
-
$795.00
Current price
$795.00
Simple Phase Contrast Kit with Achromatic Objectives offers good performance and a rich array of the most-used features all in an economical package.
The phase contrast kit with simple Achromatic Objectives improves the imaging of transparent and colourless specimens, which are difficult to see or invisible when using an regular bright field microscope specially for observing living cells, microorganisms, bacteria, molds and sperm.
Suitable for the following Microscopes:
- Optico N2000M Biological Microscope
-
Optico N2000B Binocular Microscope
-
Optico XSZ-107T Trinocular Microscope
-
Optico N120 Biological Microscope
- Optico N120MT-SP Laboratory Microscope
Specifications:
- 10X phase contrast objective: Achromatic PH10/0.25, 160/0.17 (with phase plate)
- 40X phase contrast objective: Achromatic PH40/0.65, 160/0.17 (with phase plate)
- 100X phase contrast objective: Achromatic PH100/1.25, 160/0.17, Oil (with phase plate)
- Condenser: NA1.25 ( 37mm mounting size)
- 10X condenser annular plate
- 40X condenser annular plate
- 100X condenser annular plate
- One green filter
- Centering telescopic eyepiece 23mm
- Aluminium storage case